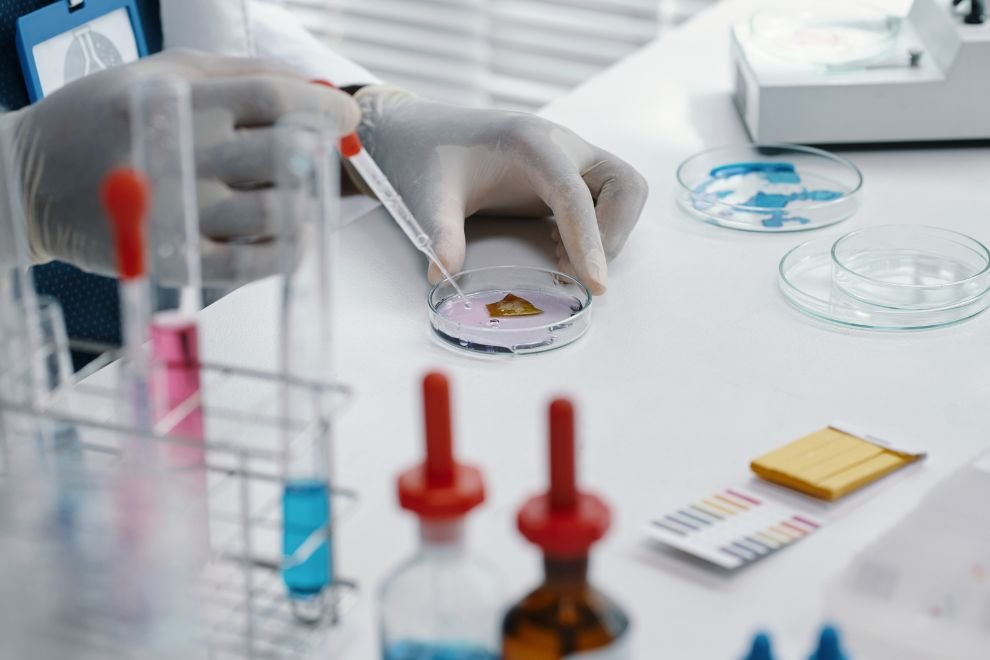

Onde a balança de precisão é utilizada e por que isso impacta seus resultados
Antes de entender as aplicações práticas da balança de precisão, é fundamental conhecer o funcionamento e os critérios corretos de escolha do equipamento.
👉 Para uma visão completa, acesse o guia completo sobre balança de precisão.
A balança de precisão é um dos equipamentos mais utilizados em ambientes laboratoriais e industriais, sendo responsável por garantir medições confiáveis em processos críticos.
Na prática, ela está diretamente ligada a:
- controle de qualidade
- padronização de processos
- conformidade regulatória
- redução de perdas
👉 Veja modelos disponíveis de balança de precisão para laboratório.
Aplicações da balança de precisão na indústria alimentícia
Na indústria de alimentos, a balança de precisão é utilizada para:
- pesagem de ingredientes
- formulação de receitas
- controle de lote
- padronização de produção
📌 Exemplo real
Uma variação mínima na pesagem de aditivos pode alterar textura, sabor e validade do produto.
👉 Confira equipamentos ideais para controle de qualidade alimentício.
Aplicações na indústria farmacêutica
Aqui, a exigência é ainda maior.
A balança de precisão é usada em:
- pesagem de matérias-primas
- controle de formulação
- desenvolvimento de medicamentos
📌 Exemplo real
Um desvio de miligramas em princípios ativos pode comprometer a eficácia do medicamento.
👉 Veja soluções para ambientes farmacêuticos.

Aplicações em laboratórios químicos
Nos laboratórios químicos, a balança de precisão é essencial para:
- preparo de soluções
- análises quantitativas
- pesagem de reagentes
Aplicações na indústria cosmética
A balança de precisão garante:
consistência de formulações
estabilidade do produto
padronização entre lotes
📌 Exemplo real
Uma pequena variação na pesagem pode alterar viscosidade e desempenho do produto final.
Aplicações em laboratórios ambientais
Utilizada em:
- análise de solo
- análise de água
- controle de contaminantes
👉 Veja opções ideais para análises ambientais.
Relação entre aplicação e escolha da balança
Cada aplicação exige um tipo específico de equipamento.
Se você ainda não definiu qual escolher, veja.

Importância da calibração nas aplicações industriais
Independentemente do setor, a calibração é essencial para garantir confiabilidade.
👉 Veja como calibrar corretamente.
Erros comuns nas aplicações industriais
Entre os principais erros estão:
- uso inadequado do equipamento
- falta de calibração
- ambiente inadequado
👉 Veja os erros mais comuns e como evitá-los.
Impacto direto da balança de precisão na qualidade
A utilização correta da balança de precisão garante:
- confiabilidade dos resultados
- redução de retrabalho
- padronização
- aumento de produtividade
Onde comprar balança de precisão confiável
A escolha do fornecedor é decisiva para garantir desempenho e durabilidade.
👉 Veja opções profissionais para laboratório.
Por que escolher a SPLABOR
A SPLABOR oferece soluções completas para laboratórios e indústrias que exigem precisão e confiabilidade.
FAQ – Aplicações da balança de precisão
Onde a balança de precisão é utilizada?
Em laboratórios, indústrias alimentícias, farmacêuticas, químicas e ambientais.
Qual a importância da balança de precisão?
Garantir medições confiáveis e padronização de processos.
A aplicação influencia na escolha?
Sim, cada aplicação exige características específicas.
A calibração é necessária em todas as aplicações?
Sim, para garantir resultados consistentes.
👉 Confira modelos ideais para diferentes aplicações.
Conclusão
As aplicações da balança de precisão vão muito além da pesagem — ela é um equipamento essencial para garantir qualidade, confiabilidade e eficiência em processos laboratoriais e industriais.
👉 Solicite agora sua cotação de balança de precisão. Nossa equipe está ON-LINE pronta para te atender.

A Splabor é uma empresa líder no ramo de fabricação de equipamentos para laboratório, especializada em oferecer uma ampla variedade de equipamentos para laboratórios, materiais e produtos para laboratório de alta qualidade.

